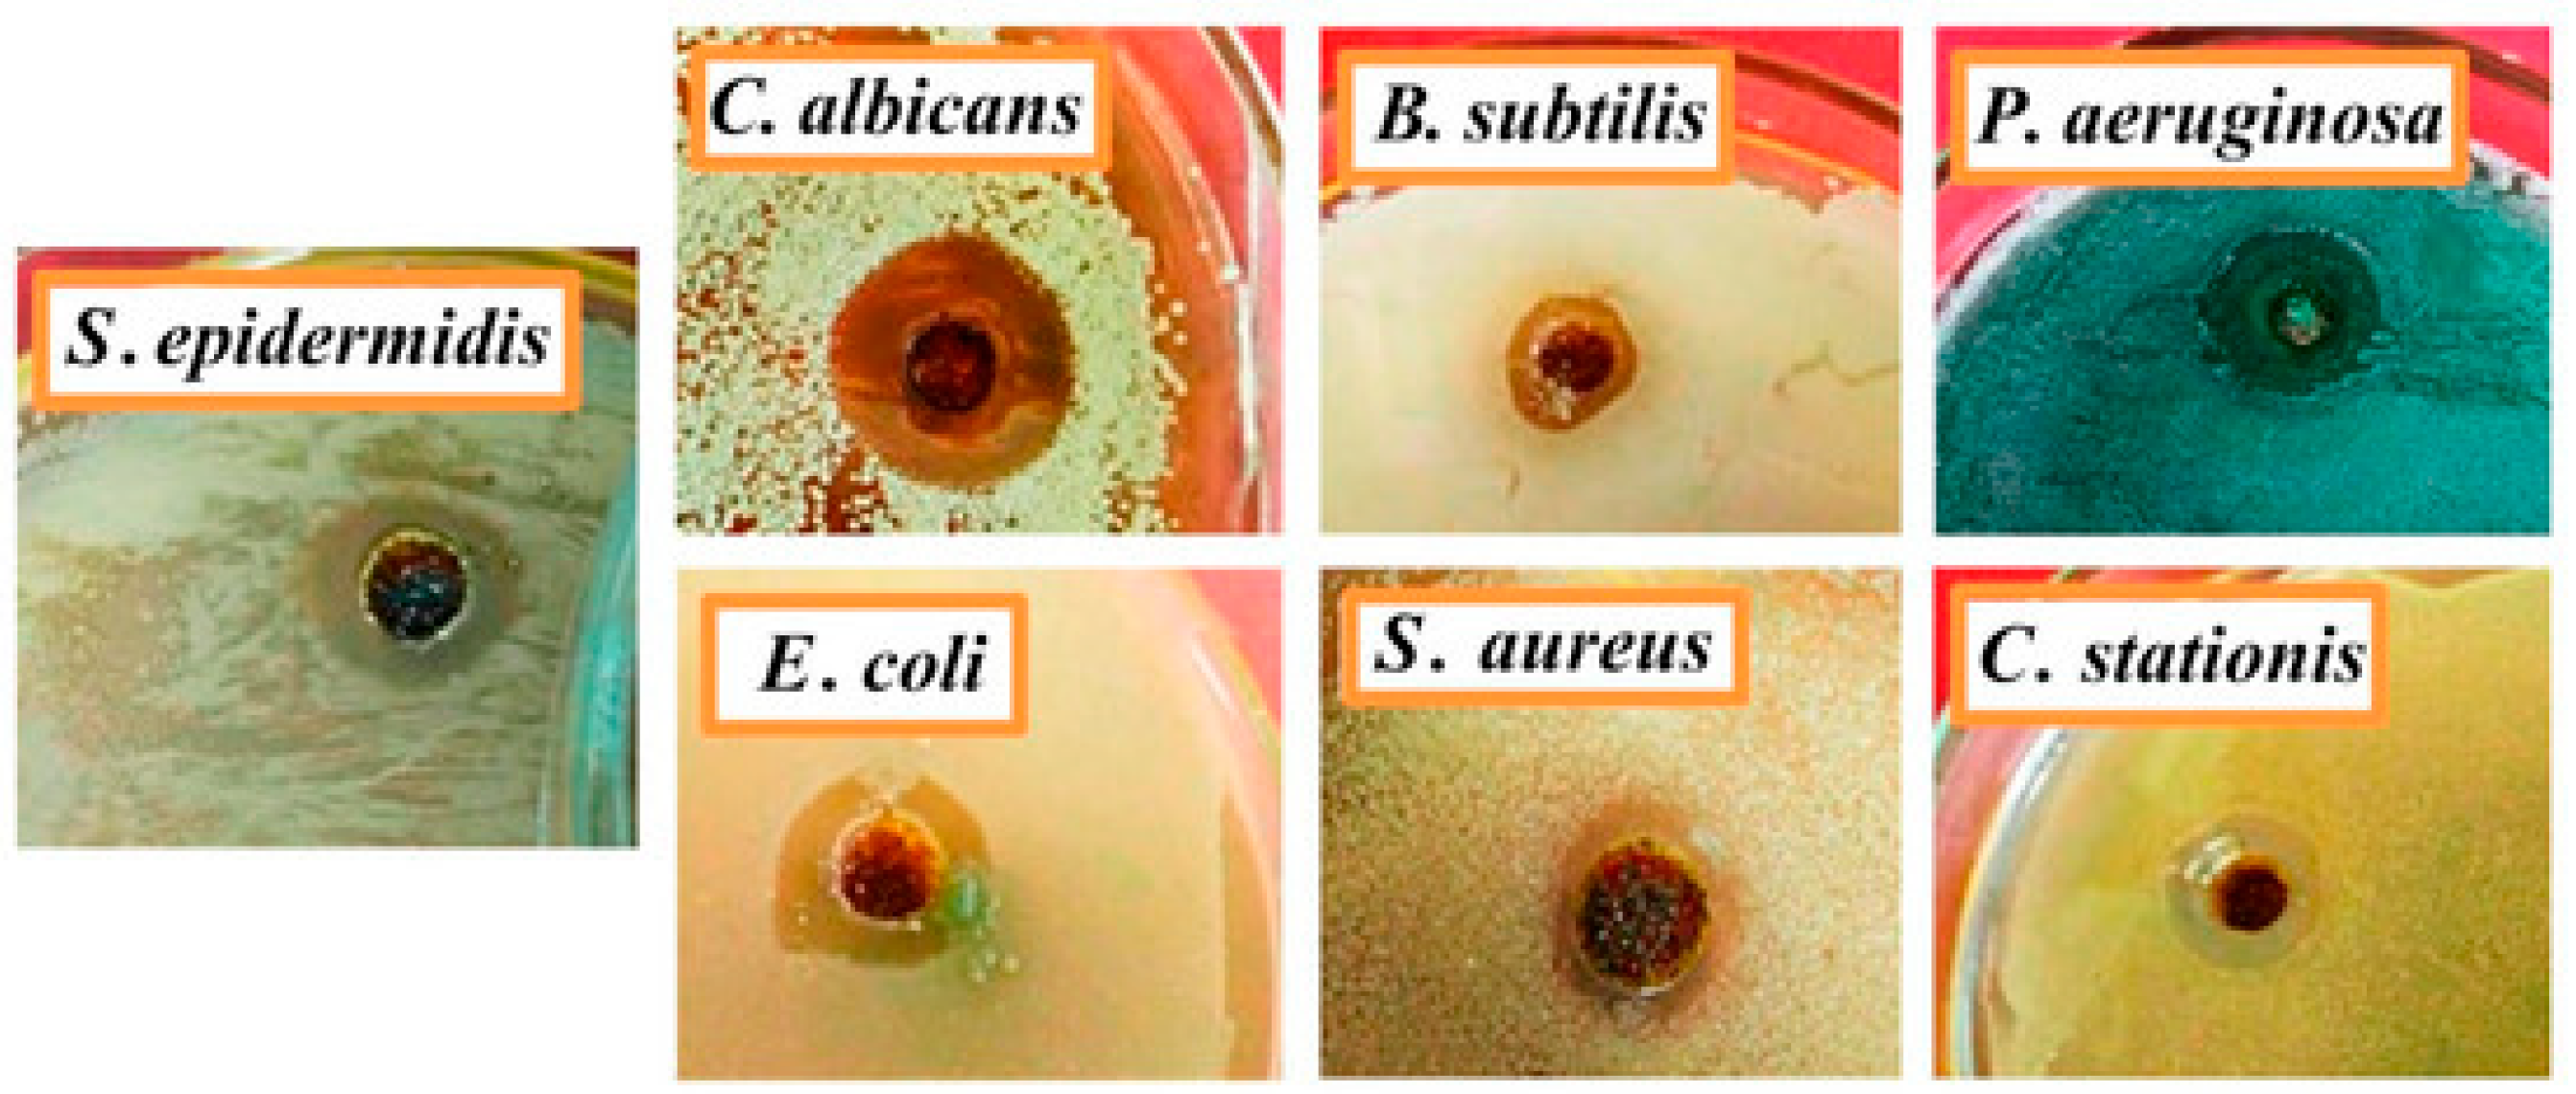
Jcs 09 00277 g017

Epoxy Resins and Their Hardeners Based on Phosphorus–Nitrogen Compounds
Abstract
1. Introduction
2. Nitrogen-Containing DOPO Derivatives
3. Nitrogen-Containing Phosphinates
4. Flame Retardants Based on Salts Containing Phosphorus and Nitrogen Atoms
5. Cyclophosphazenes
5.1. Epoxy Resins Based on Cyclophosphazenes
5.2. Hardeners for Epoxy Resins Based on Cyclophosphazenes
5.3. Prospects for the Use of Other Cyclophosphazenes as Hardeners for Epoxy Resins
6. Conclusions
Author Contributions
Funding
Data Availability Statement
Acknowledgments
Conflicts of Interest
Abbreviations
| AAP | – | arylaminocyclotriphosphazene |
| BAPh | – | bisphenol A bis(phthalonitrile) containing benzoxazine |
| BOPOA | – | epoxy resin composite |
| BP | – | binary system |
| CP-EP | – | tri(4-allyl-2-methoxyphenoxy/phenoxy) cyclotriphosphazene |
| DDM | – | 4,4′-diaminodiphenylmethane |
| DER-354 | – | bisphenol F based epoxy resin |
| DETDA | – | diethyltoluenediamine |
| DGEBA | – | bisphenol A diglycidyl ether |
| DGEBF | – | bisphenol F diglycidyl ether |
| DMP-30 | – | reaction product of diphenylphosphinic chloride and 2,4,6-tris(dimethylaminomethyl)phenol |
| DOPO | – | 9,10-dihydro-9-oxa-10-phosphaphenanthrene-10-oxide |
| DPO | – | diphenylphosphine oxide |
| DPP | – | diphenylolpropane |
| DTCATP | – | diaminotetracyclohexylaminocyclotriphosphazene |
| D230 | – | polyetheramine |
| EHEP | – | hexa[(4-(2,3-epoxypropyl)-2-methoxy)phenoxy] cyclotriphosphazene |
| HAP | – | hydroxyaryloxyphosphazene |
| HCP | – | hexachlorocyclotriphosphazene |
| HECarCP | – | hexacardanyl cyclophosphazene |
| HGCP | – | hexaglycidylcyclotriphosphazene |
| LOI | – | limiting oxygen index |
| MDA | – | 4,4′-methylene dianiline |
| NEA | – | n, n′-bis(salicylidene)ethylenediamine |
| PC-3 and LNCaP | – | human prostate cancer cell lines |
| PPCANT | – | phosphorus–nitrogen containing flame retardant |
| PPDAT | – | polymeric phosphorus/nitrogen-containing flame retardant |
| pHRR | – | peak heat release rate |
| rt | – | room temperature |
| SPR | – | smoke production rate |
| THR | – | total heat release |
| TSP | – | total smoke production |
| UP-637 | – | epoxy resorcinol resin |
| VaRTM | – | vacuum-assisted resin transfer molding |
References
- Zhang, K.; Huang, J.; Wang, Y.; Li, W.; Nie, X. Eco-Friendly Epoxy-Terminated Polyurethane-Modified Epoxy Resin with Efficient Enhancement in Toughness. Polymers 2023, 15, 2803. [Google Scholar] [CrossRef] [PubMed]
- Siahtiri, S.; Sahraei, A.A.; Mokarizadeh, A.H.; Baghani, M.; Bodaghi, M.; Baniassadi, M. Influence of Curing Agents Molecular Structures on Interfacial Characteristics of Graphene/Epoxy Nanocomposites: A Molecular Dynamics Framework. Macromol. Mater. Eng. 2023, 308, 2300030. [Google Scholar] [CrossRef]
- Zhang, L.; Liu, J.; Dai, J.; Zhang, X.; Liu, X.; Liu, X.; Yi, X. Preparation and Application of a Multifunctional Interfacial Modifier for Ramie Fiber/Epoxy Resin Composites. Polymers 2023, 15, 3800. [Google Scholar] [CrossRef] [PubMed]
- Terekhov, I.V.; Chistyakov, E.M. Binders Used for the Manufacturing of Composite Materials by Liquid Composite Molding. Polymers 2022, 14, 87. [Google Scholar] [CrossRef]
- Khan, F.; Hossain, N.; Mim, J.J.; Rahman, S.M.; Iqbal, M.J.; Billah, M.; Chowdhury, M.A. Advances of Composite Materials in Automobile Applications–A Review. J. Eng. Res. 2024; in press. [Google Scholar] [CrossRef]
- Li, X.; Wang, Q.; Cui, X.; Feng, X.; Teng, F.; Xu, M.; Su, W.; He, J. Study on the Mechanical and Toughness Behavior of Epoxy Nano-Composites with Zero-Dimensional and Two-Dimensional Nano-Fillers. Polymers 2022, 14, 3618. [Google Scholar] [CrossRef]
- Fan, C.; Chen, H.; Lin, F.; Li, W.; Xiong, X.; Chen, B.; Yu, H. Impact of Curing Time and Temperature on Bond Performance of Epoxy Resin Adhesives for Steel Bridge Decks. Polymers 2025, 17, 1018. [Google Scholar] [CrossRef]
- Shan, W.; Zhang, S. Study on the Road Performance of Terminal Carboxylated Nitrile Rubber-Modified Epoxy Asphalt Permeable Concrete. Materials 2025, 18, 1691. [Google Scholar] [CrossRef]
- Wang, F.; Zhang, Y.; Song, X.; Liu, L.; Sun, X.; Sun, P. Influence of Self-Emulsifying Waterborne Epoxy Resin with Novel Hardeners on Pore Structure and Permeability of Cement-Based Materials. Buildings 2025, 15, 997. [Google Scholar] [CrossRef]
- Cong, L.; Wang, Y.; Gao, X. Enhancing the Salt Frost Durability of Concrete with Modified Epoxy Composite Coating. Materials 2025, 18, 737. [Google Scholar] [CrossRef]
- Liu, Y.; Tang, Z.; Zhu, J. Synergistic flame retardant effect of aluminum hydroxide and ammonium polyphosphate on epoxy resin. J. Appl. Polym. Sci. 2022, 139, e53168. [Google Scholar] [CrossRef]
- Rajaei, M.; Wang, D.Y.; Bhattacharyya, D. Combined effects of ammonium polyphosphate and talc on the fire and mechanical properties of epoxy/glass fabric composites. Compos. Part B Eng. 2017, 113, 381–390. [Google Scholar] [CrossRef]
- Huang, W.; Tu, C.; Tian, Q.; Wang, K.; Yang, C.; Ma, C.; Xu, X.; Yan, W. Synergistic Effects of 9,10-Dihydro-9-oxa-10-phosphaphenanthrene-10-oxide-Based Derivative and Modified Sepiolite on Flame-Retarded Poly (Ethylene Oxide)–Poly (Butylene Adipate-Co-Terephthalate) Composites. Polymers 2024, 16, 45. [Google Scholar] [CrossRef] [PubMed]
- Yang, Y.; Lu, Y.; Zhan, W.; Kong, Q. Design of a Novel Chitosan Derivatives and DOPO Flame Retardant and Its Application in Epoxy Resin. Macromol. 2025, 5, 9. [Google Scholar] [CrossRef]
- Wang, S.; Huang, J.; Wei, A.; Chen, Y.; Lu, X.; Zou, Y.; Xu, F.; Sun, L.; Lu, Y.; Xiang, C. Synthesis of a Bimetallic-Doped Phytate-Melamine Composite as an Efficient Additive for Epoxy Resins with High Fire Safety. Polymers 2024, 16, 3586. [Google Scholar] [CrossRef]
- Lu, S.Y.; Hamerton, I. Recent developments in the chemistry of halogen-free flame retardant polymers. Prog. Polym. Sci. 2002, 27, 1661–1712. [Google Scholar] [CrossRef]
- Zhang, Y.; Wu, X.; Shi, Y.; Liao, D.; Qian, J.; Wu, C.; Song, Y. Epoxy-Functionalized Polysiloxane and DOPO Synergistically Enhance Flame Retardancy of Epoxy Resin Composites. ACS Appl. Polym. Mater. 2025, 7, 5198–5211. [Google Scholar] [CrossRef]
- Wang, X.; Zhang, J.; Fu, X.L.; Chu, F.K.; Hu, Y. Synthesis of zirconium aminotrimethylene phosphonate nanorods and their application in toughened and flame retarded epoxy composites. Compos. Part A Appl. Sci. Manuf. 2024, 179, 108059. [Google Scholar] [CrossRef]
- Branda, F.; Passaro, J.; Pauer, R.; Gaan, S.; Bifulco, A. Solvent-free one-pot synthesis of epoxy nanocomposites containing Mg (OH) 2 nanocrystal–nanoparticle formation mechanism. Langmuir 2022, 38, 5795–5802. [Google Scholar] [CrossRef]
- Artner, J.; Ciesielski, M.; Walter, O.; Döring, M.; Perez, R.M.; Sandler, J.K.W.; Schartel, B. A Novel DOPO-Based Diamine as Hardener and Flame Retardant for Epoxy Resin Systems. Macromol. Mater. Eng. 2008, 293, 503–514. [Google Scholar] [CrossRef]
- Yang, Y.; Chen, W.; Li, Z.; Huang, G.; Wu, G. Efficient flame retardancy, good thermal stability, mechanical enhancement, and transparency of DOPO-conjugated structure compound on epoxy resin. Chem. Eng. J. 2022, 450, 138424. [Google Scholar] [CrossRef]
- Yang, Q.; Wang, J.; Yang, S.; Huo, S.; Song, P.; Fang, Z.; Wang, H. A phosphorus-containing aliphatic amine curing agent towards intrinsic flame-retardant and smoke-suppressive epoxy resins. J. Polym. Res. 2023, 30, 51. [Google Scholar] [CrossRef]
- Zhao, W.; An, L.; Wang, S. Recyclable high-performance epoxy-anhydride resins with DMP-30 as the catalyst of transesterification reactions. Polymers 2021, 13, 296. [Google Scholar] [CrossRef] [PubMed]
- Li, J.; Guo, P.; Wang, Y.; Wang, Q.; Du, B. Improved high-temperature dielectric properties of DGEBA/MHHPA/DMP-30 system with optimizing postcuring process. IEEE Transact. Dielec. Elect. Insul. 2023, 30, 2150–2157. [Google Scholar] [CrossRef]
- Guo, S.; Wu, K.; Pan, Z.; Zhou, H.; Zhou, C. Flame retardant, high mechanical strength, transparent and water-resistant epoxy composites modified with chitosan derivatives. Int. J. Biol. Macromol. 2024, 260, 129580. [Google Scholar] [CrossRef]
- Yudaev, P.; Tupikov, A.; Chistyakov, E. Organocyclophosphazenes and Materials Based on Them for Pharmaceuticals and Biomedicine. Biomolecules 2025, 15, 262. [Google Scholar] [CrossRef]
- Dagdag, O.; El Bachiri, A.; Hamed, O.A.; Haldhar, R.; Verma, C.; Ebenso, E.E.; Gouri, M.E. Dendrimeric epoxy resins based on hexachlorocyclotriphosphazene as a reactive flame retardant polymeric materials: A review. J. Inorg. Organomet. Polym. Mater. 2021, 31, 3240–3261. [Google Scholar] [CrossRef]
- Kireev, V.V.; Bilichenko, Y.V.; Sirotin, I.S.; Filatov, S.N. Advances in the Synthesis of Oligomer Epoxyphosphazenes with Reduced Inflammability. Polym. Sci. Ser. B 2022, 64, 89–108. [Google Scholar] [CrossRef]
- Bifulco, A.; Varganici, C.D.; Rosu, L.; Mustata, F.; Rosu, D.; Gaan, S. Recent advances in flame retardant epoxy systems containing non-reactive DOPO based phosphorus additives. Polym. Degrad. Stabil. 2022, 200, 109962. [Google Scholar] [CrossRef]
- Malkappa, K.; Prasad, C.; Kang, C.S.; Jeong, S.G.; Sangaraju, S.; Shin, E.J.; Choi, H.Y. Recent developments of phosphorous–nitrogen-based effective intumescent flame-retardant for polymers and textiles. Polym. Bull. 2025, 1–61. [Google Scholar] [CrossRef]
- Deng, Z.; Shi, M.; Liang, Y.; Yang, X.; Huang, Z. Phosphorus-nitrogen synergistic flame retardant (PNFR) towards epoxy resin with excellent flame retardancy and satisfactory mechanical strength: An insight into pyrolysis and flame retardant mechanism. Polym. Test. 2024, 131, 108352. [Google Scholar] [CrossRef]
- Liu, N.; Wang, H.; Xu, B.; Qu, L.; Fang, D. Cross-linkable phosphorus/nitrogen-containing aromatic ethylenediamine endowing epoxy resin with excellent flame retardancy and mechanical properties. Compos. Part A App. Sci. Manuf. 2022, 162, 107145. [Google Scholar] [CrossRef]
- Xiao, Z.; Niu, H.; Wang, W.; Zhou, K.; Hu, Y.; Wang, X. Novel rich aromatic and phosphorus-containing compound cured epoxy resins toward outstanding comprehensive performances. Colloid Surf. A Physicochem. Eng. Asp. 2024, 683, 133008. [Google Scholar] [CrossRef]
- Yang, B.; Song, N.; Chen, Z.; Yu, Y.; Chen, Z.; Rong, F.; Chen, T.; Guo, Y.; Wang, K.; Feng, C.; et al. Fabrication of a cinnamaldehyde-based bi-DOPO flame retardant with excellent glass transition temperature, fire safety and mechanical properties for epoxy resins. Colloid Surf. A Physicochem. Eng. Asp. 2024, 681, 132815. [Google Scholar] [CrossRef]
- Wang, D.; Liu, Q.; Peng, X.; Liu, C.; Li, Z.; Li, Z.; Wang, R.; Zheng, P.; Zhang, H. High-efficiency phosphorus/nitrogen-containing flame retardant on epoxy resin. Polym. Degrad. Stabil. 2021, 187, 109544. [Google Scholar] [CrossRef]
- Weijie, Z.; Mutian, Z.; Yongchun, K.; Jie, C.; Yuan, H.; Weiyi, X. Synthesis and flame retardant efficiency study of two phosphorus-nitrogen type flame retardants containing triazole units. Polym. Degrad. Stabil. 2023, 208, 110236. [Google Scholar]
- Wei, L.; Zhang, X.; Min, F.; Yan, G.; Sun, X.; Xie, B.; Lu, H.; Liu, Y.; Zhao, N.; Li, Q. A flame-retardant and transparent epoxy resin based on phosphorus-containing ionic liquid and its mechanical, thermal and flame-retardant properties. React. Funct. Polym. 2024, 197, 105854. [Google Scholar] [CrossRef]
- Jiang, G.; Xiao, Y.; Qian, Z.; Yang, Y.; Jia, P.; Song, L.; Hu, Y.; Ma, C.; Gui, Z. A novel phosphorus-, nitrogen- and sulfur-containing macromolecule flame retardant for constructing high-performance epoxy resin composites. Chem. Eng. J. 2023, 451, 137823. [Google Scholar] [CrossRef]
- Rao, W.; Zhao, P.; Yu, C.; Zhao, H.-B.; Wang, Y.-Z. High strength, low flammability, and smoke suppression for epoxy thermoset enabled by a low-loading phosphorus-nitrogen-silicon compound. Compos. Part B Eng. 2021, 211, 108640. [Google Scholar] [CrossRef]
- Chen, Y.; Duan, H.; Ji, S.; Ma, H. Novel phosphorus/nitrogen/boron-containing carboxylic acid as co-curing agent for fire safety of epoxy resin with enhanced mechanical properties. J. Hazard. Mater. 2021, 402, 123769. [Google Scholar] [CrossRef]
- Zhang, L.; Xia, Y.; Sun, J.; Guo, Z.; Fang, Z.; Chen, P.; Li, J. Multi-element hybrid flame retardants balance flame retardancy and mechanical performance of epoxy coatings. Prog. Organ. Coat. 2024, 188, 108219. [Google Scholar] [CrossRef]
- Sun, J.; Wang, B.; Xia, Y.; Zhang, Y.; Guo, Z.; Fang, Z.; Chen, P. Roles of organic chain structure in flame retardancy and mechanical properties of epoxy coating. Prog. Organ. Coat. 2023, 184, 107863. [Google Scholar] [CrossRef]
- Shi, J.-C.; Bai, W.-B.; Lin, Y.-C.; Ding, F.-C.; Jian, R.-K. Synthesis of a novel dimethylglyoxime-bridged phosphinate and its application in flame-retardant epoxy resins. Polym. Degrad. Stabil. 2024, 220, 110662. [Google Scholar] [CrossRef]
- Yang, Q.; Wang, J.; Chen, X.; Yang, S.; Huo, S.; Chen, Q.; Guo, P.; Wang, X.; Liu, F.; Chen, W.; et al. Phosphorus-containing tertiary amine hardener enabled flame retardant, heat resistant and mechanically strong yet tough epoxy resins. Chem. Eng. J. 2023, 468, 143811. [Google Scholar] [CrossRef]
- Singh, M.K.; Rangappa, S.M.; Misra, M.; Mohanty, A.K.; Siengchin, S. Recent advancements in nanostructured flame-retardants: Types, mechanisms, and applications in polymer composites. Nano-Struct. Nano-Objects 2025, 42, 101468. [Google Scholar] [CrossRef]
- Yang, W.; Chang, W.; Zhang, J.; Yeoh, G.H.; Boyer, C.; Wang, C.H. Recent advances in constructing new type of epoxy resin flame retardant system using ammonium polyphosphate. J. Saf. Sci. Resil. 2024, 5, 179–193. [Google Scholar] [CrossRef]
- Wang, M.; Xiao, G.; Chen, C.; Wang, F.; Zhong, F.; Chen, C.; Yang, Z.; Zou, R. Synergistic enhancement of flame retardancy of epoxy resin by layered zirconium phenylphosphate modified layered double hydroxides. Prog. Org. Coat. 2023, 177, 107437. [Google Scholar] [CrossRef]
- Wenmu, Y.; Wenkai, C.; Jin, Z.; Guan, H.Y.; Cyrille, B.; Chun, H.W. A novel strategy for high flame retardancy and structural strength of epoxy composites by functionalizing ammonium polyphosphate (APP) using an amine-based hardener. Compos. Struct. 2024, 327, 117710. [Google Scholar] [CrossRef]
- Wang, X.; Guo, W.W.; Song, L.; Hu, Y. Intrinsically flame retardant bio-based epoxy thermosets: A review. Compos. Part B Eng. 2019, 179, 107487. [Google Scholar] [CrossRef]
- Bi, X.; Di, H.; Liu, J.; Meng, Y.F.; Song, Y.Y.; Meng, W.H.; Qu, H.; Fang, L.; Song, P.; Xu, J. A core-shell-structured APP@ COFs hybrid for enhanced flame retardancy and mechanical property of epoxy resin (EP). Adv. Compos. Hybrid Mater. 2022, 5, 1743–1755. [Google Scholar] [CrossRef]
- Yang, W.; Wu, S.; Yang, W.; Yuen, A.C.Y.; Zhou, Y.; Yeoh, G.; Boyer, C.; Wang, C.H. Nanoparticles of polydopamine for improving mechanical and flame-retardant properties of an epoxy resin. Compos. Part B Eng. 2020, 186, 107828. [Google Scholar] [CrossRef]
- Fang, F.; Ran, S.; Fang, Z.; Song, P.; Wang, H. Improved flame resistance and thermo-mechanical properties of epoxy resin nanocomposites from functionalized graphene oxide via self-assembly in water. Compos. Part B Eng. 2019, 165, 406–416. [Google Scholar] [CrossRef]
- Mathews, L.D.; Capricho, J.C.; Peerzada, M.; Salim, N.V.; Parameswaranpillai, J.; Hameed, N. Recent progress and multifunctional applications of fire-retardant epoxy resins. Mater. Today Commun. 2022, 33, 104702. [Google Scholar] [CrossRef]
- Kang, M.; Lin, W.; Liang, C.; Zeng, J.; Wang, Y.; Guan, Y.; Cheng, J. Construction of ammonium polyphosphate-modified halloysite nanotubes on phase change material microcapsules for the enhancement of thermophysical performance and flame retardant properties. Appl. Therm. Eng. 2024, 239, 122160. [Google Scholar] [CrossRef]
- Ding, Z.; Wang, S.; Ge, J.; Okoye, P.U.; Wu, W.; Chen, Q.; Meng, L.; Zhang, A.; Li, S. Flame-retardant epoxy resin: Synergistic effect between aluminum diethylphosphinate and piperazine pyrophosphate. Iran Polym. J. 2024, 33, 119–129. [Google Scholar] [CrossRef]
- Wang, D.; Xu, X.; Qiu, Y.; Wang, J.; Meng, L. Cyclotriphosphazene based materials: Structure, functionalization and applications. Prog. Mater. Sci. 2024, 142, 101232. [Google Scholar] [CrossRef]
- Yudaev, P.; Butorova, I.; Chuev, V.; Posokhova, V.; Klyukin, B.; Chistyakov, E. Wound Gel with Antimicrobial Effects Based on Polyvinyl Alcohol and Functional Aryloxycyclotriphosphazene. Polymers 2023, 15, 2831. [Google Scholar] [CrossRef]
- Ahmad, M.; Nawaz, T.; Hussain, I.; Chen, X.; Imran, M.; Hussain, R.; Wu, Z. Phosphazene Cyclomatrix Network-Based Polymer: Chemistry, Synthesis, and Applications. ACS Omega 2022, 7, 28694–28707. [Google Scholar] [CrossRef]
- Chen, F.; Teniola, O.R.; Laurencin, C.T. Biodegradable polyphosphazenes for regenerative engineering. J. Mater. Res. 2022, 37, 1417–1428. [Google Scholar] [CrossRef]
- Jin, G.W.; Rejinold, N.S.; Choy, J.H. Polyphosphazene-Based Biomaterials for Biomedical Applications. Int. J. Mol. Sci. 2022, 23, 15993. [Google Scholar] [CrossRef]
- Chistyakov, E.M.; Kolpinskaya, N.; Posokhova, V.; Chuev, V. Dental composition modified with aryloxyphosphazene containing carboxyl groups. Polymers 2020, 12, 1176. [Google Scholar] [CrossRef] [PubMed]
- Chistyakov, E.M.; Panfilova, D.V.; Kireev, V.V.; Volkov, V.V.; Bobrov, M.F. Synthesis and properties of hexakis-(β-carboxyethenylphenoxy) cyclotriphosphazene. J. Mol. Struct. 2017, 1148, 1–6. [Google Scholar] [CrossRef]
- Chistyakov, E.M.; Filatov, S.N.; Kireev, V.V.; Prudskov, B.M.; Chetverikova, A.I.; Chuev, V.P.; Borisov, R.S. Methacrylate composites containing maleic derivatives of cyclotriphosphazene. Polym. Sci. Ser. B 2013, 55, 355–359. [Google Scholar] [CrossRef]
- Chistyakov, E.M.; Panfilova, D.V.; Kireev, V.V. Carboxyl derivatives of phosphazenes. Russ. J. Gen. Chem. 2017, 87, 997–1006. [Google Scholar] [CrossRef]
- Casella, G.; Carlotto, S.; Lanero, F.; Mozzon, M.; Sgarbossa, P.; Bertani, R. Cyclo-and Polyphosphazenes for Biomedical Applications. Molecules 2022, 27, 8117. [Google Scholar] [CrossRef]
- Doğan, H.; Bahar, M.R.; Çalışkan, E.; Tekin, S.; Uslu, H.; Akman, F.; Koran, K.; Sandai, S.; Görgülü, A.O. Synthesis and spectroscopic characterizations of hexakis [(1-(4′-oxyphenyl)-3-(substituted-phenyl) prop-2-en-1-one)] cyclotriphosphazenes: Their in vitro cytotoxic activity, theoretical analysis and molecular docking studies. J. Biomol. Struct. Dyn. 2022, 40, 3258–3272. [Google Scholar] [CrossRef]
- Ture, S.; Darcan, C.; Türkyılmaz, O.; Kaygusuz, Ö. Synthesis, structural characterization and antimicrobial activities of cyclochlorotriphosphazene derivatives derived from N-(1-Naphthyl) ethylenediamine. Phosphorus Sulfur Silicon Relat. Elem. 2020, 195, 507–515. [Google Scholar] [CrossRef]
- Maslennikova, V.V.; Filatov, S.N.; Orlov, A.V.; Surin, N.M.; Svidchenko, E.A.; Chistyakov, E.M. Luminescent Coatings Based on (3-Aminopropyl) triethoxysilane and Europium Complex β-Diketophosphazene. Polymers 2022, 14, 728. [Google Scholar] [CrossRef]
- Chistyakov, E.M.; Tupikov, A.S.; Buzin, M.I.; Borisov, R.S.; Kireev, V.V. Preparation of films based on β-diketophosphazene and different amines and study their properties. Mater. Chem. Phys. 2019, 223, 353–359. [Google Scholar] [CrossRef]
- Nikovskii, I.A.; Chistyakov, E.M.; Tupikov, A.S. Phosphazene-containing ligands and complexes on their base. Russ. J. Gen. Chem. 2018, 88, 474–494. [Google Scholar] [CrossRef]
- Uslu, A.; Yeşilot, S. Recent advances in the supramolecular assembly of cyclophosphazene derivatives. Dalton Trans. 2021, 50, 2324–2341. [Google Scholar] [CrossRef] [PubMed]
- Yudaev, P.; Butorova, I.; Stepanov, G.; Chistyakov, E. Extraction of Palladium (II) with a Magnetic Sorbent Based on Polyvinyl Alcohol Gel, Metallic Iron, and an Environmentally Friendly Polydentate Phosphazene-Containing Extractant. Gels 2022, 8, 492. [Google Scholar] [CrossRef]
- İbişoğlu, H.; Atilla, D.; Tümay, S.O.; Şenocak, A.; Duygulu, E.; Yuksel, F. New cyclotriphosphazene ligand containing imidazole rings and its one-dimensional copper (II) coordination polymer. J. Mol. Struct. 2020, 1208, 127888. [Google Scholar] [CrossRef]
- Uslu, A.; Tümay, S.O.; Yeşilot, S. Fluorescent materials based on phosphazene derivatives and their applications: Sensors and optoelectronic devices. J. Photochem. Photobiol. C Photochem. Rev. 2022, 53, 100553. [Google Scholar] [CrossRef]
- Davarcı, D.; Doganci, E. Liquid crystal phosphazenes. J. Mol. Struct. 2022, 1269, 133819. [Google Scholar] [CrossRef]
- Erkovan, A.O.; Seifi, A.; Aksoy, B.T.; Khataee, A.; Zorlu, Y.; Çoşut, B. Catalytic activation of persulfate by 3D Cd (II) coordination polymers based on a flexible cyclotriphosphazene-functionalized ligand. Polyhedron 2023, 241, 116472. [Google Scholar] [CrossRef]
- Erkovan, A.O.; Seifi, A.; Aksoy, B.T.; Zorlu, Y.; Khataee, A.; Çoşut, B. Catalytic Activity of Zn(II) Coordination Polymer Based on a Cyclotriphosphazene-Functionalized Ligand for Removal of Organic Dyes. Catalysts 2023, 13, 756. [Google Scholar] [CrossRef]
- Dagdag, O.; Kim, H. Progress in the Field of Cyclophosphazenes: Preparation, Properties, and Applications. Polymers 2024, 16, 122. [Google Scholar] [CrossRef]
- Chistyakov, E.M.; Kireev, V.V.; Filatov, S.N.; Terekhov, I.V.; Buzin, M.I.; Komarova, L.I. Thermal polycondensation of hexa-p-hydroxymethylphenoxycyclotriphosphazene. Polym. Sci. Ser. B 2012, 54, 407–412. [Google Scholar] [CrossRef]
- Terekhov, I.V.; Chistyakov, E.M.; Filatov, S.N.; Borisov, R.S.; Kireev, V.V. Synthesis of hexakis (hydroxyaryloxy) cyclotriphosphazene based on bisphenol A. Mendeleev Commun. 2014, 24, 154–155. [Google Scholar] [CrossRef]
- Chistyakov, E.M.; Buzin, M.I.; Aksenov, S.M.; Tupikov, A.S.; Kireev, V.V. Thermal polycondensation of hexakis (p-acetylphenoxy)-cyclotriphosphazene. Mendeleev Commun. 2019, 29, 99–101. [Google Scholar] [CrossRef]
- Kireev, V.V.; Chistyakov, E.M.; Filatov, S.N.; Tupikov, A.S.; Panfilova, D.V.; Chetverikova, A.I. Polymeric dental composites modified with carboxy phosphazene methacrylates. Russ. J. Appl. Chem. 2015, 88, 866–870. [Google Scholar] [CrossRef]
- Panfilova, D.V.; Chistyakov, E.M.; Filatov, S.N.; Typikov, A.S.; Buzin, M.I. Evaluation of thermal properties of carboxyphenoxycyclotriphosphazenes. Int. Multidiscip. Sci. GeoConf. SGEM 2016, 1, 103–109. [Google Scholar]
- Yudaev, P.; Konstantinova, A.; Volkov, V.; Chistyakov, E. Hexakis-2-(β-carboxyethenylphenoxy) cyclotriphosphazene: Synthesis, Properties, Modeling Structure. Molecules 2023, 28, 6571. [Google Scholar] [CrossRef]
- Bobrov, M.F.; Buzin, M.I.; Primakov, P.V.; Chistyakov, E.M. Investigation of hexakis [2-formylphenoxy] cyclotriphosphazene structure by single crystal X-ray diffraction and computer simulation. J. Mol. Struct. 2020, 1208, 127896. [Google Scholar] [CrossRef]
- Chistyakov, E.; Yudaev, P.; Nelyubina, Y. Crystallization of Nano-Sized Macromolecules by the Example of Hexakis-[4-{(N-Allylimino) methyl} phenoxy] cyclotriphosphazene. Nanomaterials 2022, 12, 2268. [Google Scholar] [CrossRef]
- Seraji, S.M.; Gan, H.; Swan, S.R.; Varley, R.J. Phosphazene as an effective flame retardant for rapid curing epoxy resins. React. Funct. Polym. 2021, 164, 104910. [Google Scholar] [CrossRef]
- Waldin, N.A.; Jamain, Z. The Effect of Alkyl Terminal Chain Length of Schiff-Based Cyclotriphosphazene Derivatives towards Epoxy Resins on Flame Retardancy and Mechanical Properties. Polymers 2023, 15, 1431. [Google Scholar] [CrossRef]
- Wu, X.; Jiang, G.; Zhang, Y.; Wu, L.; Jia, Y.; Tan, Y.; Liu, J.; Zhang, X. Enhancement of Flame Retardancy of Colorless and Transparent Semi-Alicyclic Polyimide Film from Hydrogenated-BPDA and 4,4′-oxydianiline via the Incorporation of Phosphazene Oligomer. Polymers 2020, 12, 90. [Google Scholar] [CrossRef]
- Yang, Y.; Zhang, Q.; Hao, Y.; Lan, X.; Haurie, L.; Zheng, D.; Huang, G. Preparation of a cyclotriphosphazene microsphere bearing a phosphaphenanthrene structure towards fire-safety and mechanical enhancement for epoxy and its aramid fiber composite. Mater. Adv. 2024, 5, 2860–2871. [Google Scholar] [CrossRef]
- Wei, Y.; Zhu, S.; Qian, Q.; Jiang, Q.; Zhang, L.; Jin, K.; Qiu, Y. Hexachlorocyclotriphosphazene functionalized lignin as a sustainable and effective flame retardant for epoxy resins. Ind. Crops Prod. 2022, 187, 115543. [Google Scholar] [CrossRef]
- Nabipour, H.; Wang, X.; Rahman, M.Z.; Song, L.; Hu, Y. Improvement of the flame retardant and thermomechanical properties of epoxy resins by a vanillin-derived cyclotriphosphazene-cored triazole compound. Polym. Degrad. Stabil. 2022, 204, 110088. [Google Scholar] [CrossRef]
- El Gouri, M.; El Bachiri, A.; Hegazi, S.E.; Rafik, M.; El Harfi, A. Thermal degradation of a reactive flame retardant based on cyclotriphosphazene and its blend with DGEBA epoxy resin. Polym. Degrad. Stabil. 2009, 94, 2101–2106. [Google Scholar] [CrossRef]
- El Gouri, M.; El Bachiri, A.; Hegazi, S.E.; Ziraoui, R.; Rafik, M.; El Harfi, A. A phosphazene compound multipurpose application-Composite material precursor and reactive flame retardant for epoxy resin materials. J. Mater. Environ. Sci. 2011, 2, 319–334. [Google Scholar]
- Dagdag, O.; El Harfi, A.; Safi, Z.; Guo, L.; Kaya, S.; Verma, C.; El Gouri, M. Cyclotriphosphazene based dendrimeric epoxy resin as an anti-corrosive material for copper in 3% NaCl: Experimental and computational demonstrations. J. Mol. Liq. 2020, 308, 113020. [Google Scholar] [CrossRef]
- Dagdag, O.; El Gouri, M.; Safi, Z.S.; Wazzan, N.; Safi, S.K.; Jodeh, S.; Ebenso, E.E. Flame retardancy of an intumescent epoxy resin containing cyclotriphosphazene: Experimental, computational and statistical studies. Iran. Polym. J. 2021, 30, 1169–1179. [Google Scholar] [CrossRef]
- Liu, H.; Wang, X.; Wu, D. Novel cyclotriphosphazene-based epoxy compound and its application in halogen-free epoxy thermosetting systems: Synthesis, curing behaviors, and flame retardancy. Polym. Degrad. Stabil. 2014, 103, 96–112. [Google Scholar] [CrossRef]
- Xu, G.R.; Xu, M.J.; Li, B. Synthesis and characterization of a novel epoxy resin based on cyclotriphosphazene and its thermal degradation and flammability performance. Polym. Degrad. Stabil. 2014, 109, 240–248. [Google Scholar] [CrossRef]
- Sirotin, I.S.; Bilichenko, Y.V.; Brigadnov, K.A.; Kireev, V.V.; Suraeva, O.V.; Borisov, R.S. Oligomeric hydroxy-aryloxy phosphazene based on cyclic chlorophosphazenes. Russ. J. Appl. Chem. 2013, 86, 1903–1912. [Google Scholar] [CrossRef]
- Sirotin, I.S.; Bilichenko, Y.V.; Brigadnov, K.A.; Kireev, V.V.; Prudskov, B.M.; Borisov, R.S. Single-stage synthesis of phosphazene-containing epoxy oligomers. Polym. Sci. Ser. B 2014, 56, 471–476. [Google Scholar] [CrossRef]
- Sirotin, I.S.; Son, V.X.; Gorbunova, E.A.; Borisov, R.S.; Bilichenko, Y.V.; Kuznetsova, T.I.; Kireev, V.V. The Composition and Some Properties of Epoxy Oligomers Based on Hexachlorocyclotriphosphazene and Diphenylolpropane. Polym. Sci. Ser. D 2022, 15, 457–463. [Google Scholar] [CrossRef]
- Kireev, V.V.; Bilichenko, Y.V.; Borisov, R.S.; Sirotin, I.S.; Filatov, S.N. Laser Mass Spectrometry Analysis of the Formation of Phosphazene-Containing Epoxy Oligomers. Polym. Sci. Ser. B 2018, 60, 243–262. [Google Scholar] [CrossRef]
- Kireev, V.V.; Bilichenko, Y.V.; Borisov, R.S.; Mu, J.; Kuznetsov, D.A.; Eroshenko, A.V.; Filatov, S.N.; Sirotin, I.S. Synthesis of Bisphenol A Based Phosphazene-Containing Epoxy Resin with Reduced Viscosity. Polymers 2019, 11, 1914. [Google Scholar] [CrossRef] [PubMed]
- Sarychev, I.A.; Sirotin, I.S.; Borisov, R.S.; Mu, J.; Sokolskaya, I.B.; Bilichenko, J.V.; Filatov, S.N.; Kireev, V.V. Synthesis of Resorcinol-Based Phosphazene-Containing Epoxy Oligomers. Polymers 2019, 11, 614. [Google Scholar] [CrossRef]
- Kireev, V.V.; Chistyakov, E.M.; Filatov, S.N.; Borisov, R.S.; Prudskov, B.M. Synthesis and modification of oligo (aryloxycyclotriphosphazenes) based on 4, 4′-dihydroxydiphenyl-2, 2-propane. Polym. Sci. Ser. B 2011, 53, 412–419. [Google Scholar] [CrossRef]
- Tarasov, I.V.; Oboishchikova, A.V.; Borisov, R.S.; Kireev, V.V.; Sirotin, I.S. Phosphazene-Containing Epoxy Resins Based on Bisphenol F with Enhanced Heat Resistance and Mechanical Properties: Synthesis and Properties. Polymers 2022, 14, 4547. [Google Scholar] [CrossRef]
- Terekhov, I.V.; Chistyakov, E.M.; Filatov, S.N.; Deev, I.S.; Kurshev, E.V.; Lonskii, S.L. Factors Influencing the Fire-Resistance of Epoxy Compositions Modified with Epoxy-Containing Phosphazenes. Inorg. Mater. Appl. Res. 2019, 10, 1429–1435. [Google Scholar] [CrossRef]
- Terekhov, I.V.; Filatov, S.N.; Chistyakov, E.M.; Borisov, R.S.; Kireev, V.V. Synthesis of oligomeric epoxycyclotriphosphazenes and their properties as reactive flame-retardants for epoxy resins. Phosphorus Sulfur Silicon Relat. Elem. 2017, 192, 544–554. [Google Scholar] [CrossRef]
- Terekhov, I.V.; Filatov, S.N.; Chistyakov, E.M.; Borisov, R.S.; Kireev, V.V. Halogenated hydroxy-aryloxy phosphazenes and epoxy oligomers based on them. Russ. J. Appl. Chem. 2013, 86, 1600–1604. [Google Scholar] [CrossRef]
- Chistyakov, E.M.; Filatov, S.N.; Yudaev, P.A.; Kireev, V.V. Synthesis, characterization and epoxidation of hexakis-4-(2-(4-((β-methallyl) oxy) phenyl) propan-2-yl) phenoxycyclotriphosphazene. Tetrahedron Lett. 2019, 60, 444–448. [Google Scholar] [CrossRef]
- Wang, J.; Liu, W.; Liu, H.; Wang, X.; Wu, D.; Zhang, S.; Wu, Z. Cyclotriphosphazene-based epoxy resins with excellent mechanical and flame retardant properties. Polymer 2022, 261, 12539. [Google Scholar] [CrossRef]
- Jiang, G.; Xiao, Y.; Ma, C.; Jia, P.; Song, L.; Hu, Y.; Gui, Z. Construstion of a Phosphazene-Based Flame Retardant with Reactive Epoxy Group and its Application Achieves the Toughness Enhancement. Strength Enhanc. Fire Saf. Epoxy Resin 2022, 1–44. [Google Scholar] [CrossRef]
- Huang, J.; Guo, W.; Wang, X.; Song, L.; Hu, Y. Intrinsically flame retardant cardanol-based epoxy monomer for high-performance thermosets. Polym. Degrad. Stabil. 2021, 186, 109519. [Google Scholar] [CrossRef]
- Liu, J.; He, Z.; Wu, G.; Zhang, X.; Zhao, C.; Lei, C. Synthesis of a novel nonflammable eugenol-based phosphazene epoxy resin with unique burned intumescent char. Chem. Eng. J. 2020, 390, 124620. [Google Scholar] [CrossRef]
- Liu, J.; Zhang, X.; Liu, S.; Lei, C. Char structure and charring mechanism of phosphazene-based epoxy resin during combustion. Polym. Degrad. Stabil. 2022, 200, 109927. [Google Scholar] [CrossRef]
- Kireev, V.V.; Bredov, N.S.; Bilichenko, Y.V.; Lysenko, K.A.; Borisov, R.S.; Chuev, V.P. Epoxy oligomers based on eugenol cyclotriphosphazene derivatives. Polym. Sci. Ser. A 2008, 50, 609–615. [Google Scholar] [CrossRef]
- Caillol, S.; Boutevin, B.; Auvergne, R. Eugenol, a developing asset in biobased epoxy resins. Polymer 2021, 223, 123663. [Google Scholar] [CrossRef]
- Sirotin, I.S.; Bilichenko, Y.V.; Solodukhin, A.N.; Kireev, V.V.; Buzin, M.I.; Borisov, R.S. Eugenol derivatives of higher chlorocyclophosphazenes and related epoxy oligomers. Polym. Sci. Ser. B 2013, 55, 241–251. [Google Scholar] [CrossRef]
- Xu, M.J.; Xu, G.R.; Leng, Y.; Li, B. Synthesis of a novel flame retardant based on cyclotriphosphazene and DOPO groups and its application in epoxy resins. Polym. Degrad. Stabil. 2016, 123, 105–114. [Google Scholar] [CrossRef]
- Qian, L.; Ye, L.; Qiu, Y.; Qu, S. Thermal degradation behavior of the compound containing phosphaphenanthrene and phosphazene groups and its flame retardant mechanism on epoxy resin. Polymer 2011, 52, 5486–5493. [Google Scholar] [CrossRef]
- Rybyan, A.A.; Bilichenko, J.V.; Kireev, V.V.; Kolenchenko, A.A.; Chistyakov, E.M. Curing of DER-331 Epoxy Resin with Arylaminocyclotriphosphazenes Based on o-, m-, and p-methylanilines. Polymers 2022, 14, 5334. [Google Scholar] [CrossRef] [PubMed]
- Miao, Z.; Yan, D.; Wang, X.; Zhang, X.; Zhou, W.; Qiu, M.; Wu, Z. New flame retardant epoxy resins based on cyclophosphazene-derived curing agents. Chin. Chem. Let. 2022, 33, 4026–4032. [Google Scholar] [CrossRef]
- Zarybnicka, L.; Machotova, J.; Kopecka, R.; Sevcik, R.; Hudakova, M.; Pokorny, J.; Sal, J. Effect of Cyclotriphosphazene-Based Curing Agents on the Flame Resistance of Epoxy Resins. Polymers 2021, 13, 8. [Google Scholar] [CrossRef] [PubMed]
- Chistyakov, E.M.; Terekhov, I.V.; Shapagin, A.V.; Filatov, S.N.; Chuev, V.P. Curing of Epoxy Resin DER-331 by Hexakis (4-acetamidophenoxy) cyclotriphosphazene and Properties of the Prepared Composition. Polymers 2019, 11, 1191. [Google Scholar] [CrossRef]
- Terekhov, I.V.; Chistyakov, E.M.; Filatov, S.N.; Kireev, V.V.; Buzin, M.I. Hexa-para-aminophenoxycyclo-triphosphazene as a curing agent/modifier for epoxy resins. Int. Polymer Sci. Technol. 2015, 42, 31–34. [Google Scholar] [CrossRef]
- Orlov, A.; Konstantinova, A.; Korotkov, R.; Yudaev, P.; Mezhuev, Y.; Terekhov, I.; Chistyakov, E. Epoxy Compositions with Reduced Flammability Based on DER-354 Resin and a Curing Agent Containing Aminophosphazenes Synthesized in Bulk Isophoronediamine. Polymers 2022, 14, 3592. [Google Scholar] [CrossRef]
- Konstantinova, A.; Yudaev, P.; Orlov, A.; Loban, O.; Lukashov, N.; Chistyakov, E. Aryloxyphosphazene-Modified and Graphite-Filled Epoxy Compositions with Reduced Flammability and Electrically Conductive Properties. J. Compos. Sci. 2023, 7, 417. [Google Scholar] [CrossRef]
- Yang, W.; Kim, J. Enhancing through-plane thermal conductivity of epoxy-based composites via surface treatment of boron nitride cured with a flame retardant phosphazene-based curing agent. Compos. Part A Appl. Sci. Manuf. 2023, 168, 107481. [Google Scholar] [CrossRef]
- Fan, W.; Li, Z.; Liao, Q.; Zhang, L.; Kong, L.; Yang, Z.; Xiang, M. Improving the Heat Resistance and Flame Retardancy of Epoxy Resin Composites by Novel Multifunctional Cyclophosphazene Derivatives. Polymers 2022, 15, 59. [Google Scholar] [CrossRef]
- Konstantinova, A.; Yudaev, P.; Shapagin, A.; Panfilova, D.; Palamarchuk, A.; Chistyakov, E. Non-Flammable Epoxy Composition Based on Epoxy Resin DER-331 and 4-(β-Carboxyethenyl)phenoxy-phenoxycyclotriphosphazenes with Increased Adhesion to Metals. Science 2024, 6, 30. [Google Scholar] [CrossRef]

| Epoxy Composition Sample Name | Flame Retardant Loading, wt.% | LOI, % | UL-94 | PHRR, kW/m2 | THR, MJ/m2 | TSP, m2 | Ref. |
|---|---|---|---|---|---|---|---|
| DGEBA/DDM * | - | 21.8 | NR | 814 | 115.5 | - | [31] |
BOPOA-1.5![]() | 12.8 | 30 | V-0 | 611 (−25%) | 87.4 (−24%) | - | |
| DGEBA/DDM * | - | 27.8 | NR | 2312 | 130.6 | 18.3 | [32] |
EP/BCI/BSEA-4![]() | 4 | 32.1 | V-0 | 765 (−67%) | 81.7 (−37%) | 20.1 (+10%) | |
| DGEBA/DDM * | - | 25.5 | NR | 1136 | 139.7 | 28.8 | [33] |
EP/5.0 DOPO-CC![]() | 5 | 33.5 | V-0 | 726 (−66%) | 88.3 (−65%) | 21.6 (−78%) | |
| DGEBA/DDS * | - | 21.7 | NR | 1064 | 97.1 | - | [35] |
| 5DOPO-BAPh/EP | 3.8 | 35.8 | V-0 | 693 (−35%) | 96.2 (−1%) | - | |
20DOPO-BAPh/EP![]() | 13.6 | 41.2 | V-0 | 266 (−75%) | 69.1 (−28%) | - | |
| DGEBA/DDM * | - | 25 | NR | 1317 | 84 | 12.7 | [36] |
EP/N-DOPO 7.5![]() | 7.5 | 33.5 | V-0 | 1059 (−20%) | 66.8 (−20%) | 8.2 (−35%) | |
| DGEBA/DDM * | - | 25.3 | NR | 1102 | - | 18.9 | [37] |
| EP/3% DOPA-MZ | 3 | 30.3 | V-0 | 1262 (+14%) | - | 14.4 (−24%) | |
EP/5% DOPA-MZ![]() | 5 | 31.2 | V-0 | 1065 (−3%) | - | 15.1 (−20%) | |
| DGEBA/DDM * | - | 25.5 | NR | 1248 | 93.4 | 28.4 | [38] |
EP/10% DOPONH2-S![]() | 10 | 33.5 | V-0 | 510 (−59.1%) | 38.8 (−58.5%) | 43.4 | |
| DGEBA/DDM * | - | 21 | NR | 1050 | 96 | 31 | [39] |
9% DP-PPD/EP![]() | 9 | 31.5 | V-0 | 720 (−31%) | 62 (−35%) | 25 (−19%) | |
| DGEBA/MeTHPA /DMP-30 * | - | 20.1 | NR | 1149 | 86.3 | 32.2 | [40] |
TMDB/EP![]() | 15.1 | 29.6 | V-0 | 477 (−58%) | 50.3 (−42%) | 17 (−47%) | |
| DGEBA/DDM * | - | 26.5 | NR | 1126 | 98.7 | 39.8 | [41,42] |
| EP/3BSiP | 3 | 31.5 | V-0 | 845 (−25%) | 90.4 (−8%) | 37.1 (−7%) | |
| EP/2BSiP/2BP | 4 | 33 | V-0 | - | - | - | |
EP/3BSiP/3BP![]() | 6 | 33.6 | V-0 | 556 (−51%) | 76.6 (−22%) | 32.1 (−19%) | |
| DGEBA/DDS * | - | 22.2 | NR | 1065 | 74.5 | 29.6 | [43] |
EP/DMG-DC-15![]() | 15 | 28.4 | V-0 | 489 (−55%) | 48.3 (−35%) | 33.9 (+14%) | |
| DGEBA/DMP-30 * | - | 20.1 | NR | 1647 | 119.3 | 24.5 | [44] |
EP/DCM-1.5![]() | - | 35.7 | V-0 | 1050 (−36.2%) | 75.2 (−37%) | 21.0 (−14.3%) | |
| DGEBA/DDM * | - | - | - | 708 | 105.9 | 30.3 | [46] |
| spherical microcapsules based on functionalized ammonium polyphosphate a-MPCMs/EP | 5 | - | - | 602 (−15%) | 101.5 (−4%) | 29.6 (−2%) | |
| DGEBA/DDM * | - | 25 | - | 1438 | 93.1 | - | [47] |
| 3 wt% zirconium aminotrimethylene phosphonate ZrATMP-EP | 3 | 28 | - | 1001 (−30%) | 56.6 (−39%) | - |
| Sample | T5%, °C (in Nitrogen) | Flexural Strength, MPa | Tensile Strength, MPa | Impact Strength, kJ/m2 | Reference |
|---|---|---|---|---|---|
| DGEBA/DDM | 358 | 122 | 105 | 13 | [31] |
| BOPOA-1.5 | 310 | 52 | 26 | 7 | |
| DGEBA/DDM | 349 | - | 70 | - | [32] |
| EP/BCI/BSEA-4 | 218 | - | 106 (+51%) | - | |
| DGEBA/DDM | 388 | - | 37 | 16 | [33] |
| EP/5.0 DOPO-CC | 369 | - | 57 (+54%) | 18 | |
| DGEBA/DDS | 382 | - | - | - | [35] |
| 5DOPO-BAPh/EP | 381 | - | - | - | |
| DGEBA/DDM | [36] | ||||
| EP/N-DOPO 7.5 | 317 | - | - | - | |
| DGEBA/DDM | 364 | 84 | 73 | - | [37] |
| EP/5% DOPA-MZ | 344 | 104 (+24%) | 88 (+21%) | - | |
| DGEBA/DDM | 348 | - | 45 | 7 | [38] |
| EP/10% DOPONH2-S | 370 (+6.2%) | - | 37 | 12 | |
| DGEBA/DDM | 384 | 119 | - | 19 | |
| 9% DP-PPD/EP | 343 | 110 (−7.5%) | - | 18 | [39] |
| DGEBA/MeTHPA /DMP-30 | 357 | 110 | 50 | - | [40] |
| EP/15.1% TMDB | 350 | 120 (+9%) | 70 | - | |
| DGEBA/DDM | 372 | 107 | 73 | 5 | [41,42] |
| EP/3BSiP | 359 | 132 (+23%) | 69 | 6 | |
| EP/2BSiP/2BP | - | 125 | 65 | 7 | |
| EP/3BSiP/3BP | - | 115 | 66 | 12 |
| Sample | T5%, °C (in Nitrogen) | Flexural Strength, MPa | Tensile Strength, MPa | Impact Strength, kJ/m2 | Reference |
|---|---|---|---|---|---|
| DGEBA/DDS | 359 | - | - | - | [43] |
| EP/DMG-DC-15 | 320 | - | - | - | |
| DGEBA/DMP-30 | 349 | 81.0 | 49.5 | 6.8 | [44] |
| EP/DCM-1.5 | 293 | 112.5 (+38.9%) | 77.1 (+55.8%) | 21.4 (+214.7%) |
| Epoxyphosphazene, Structure, Epoxy Resin | Hardener | LOI, vol.% | Flaming Drips Igniting Cotton (UL-94) | References |
|---|---|---|---|---|
![]() X = 4, R=Cl and epoxy resin ED-22 | Ethylenediamine | 23.9–33.5 | None | [107,110] |
![]() X = 4, R=Cl and epoxy resin ED-22 | IMTHPA | 24.9–29.6 | None | |
| Epoxy resin ED-22 | Ethylenediamine | 22.3 | Yes | |
![]() R=H or Cl and epoxy resin DER-330 | IMTHPA | - | None | [109] |
| Epoxy Composition | LOI, % | UL-94 | PHRR, kW/m2 | TSP, m2 | THR, MJ/m2 | Ref. |
|---|---|---|---|---|---|---|
| E44/DDM + DETDA (control) | 21.3 | - | 578.21 | 23.9 | 62.5 | [111] |
| E44 (227 g/equiv.)/CP-EP/DDM + DETDA | 27.7 | V-0 | 379.58 (−34%) | 10.4 (−56%) | 31.0 (−50%) | |
| DGEBA/DDM | 25.0 | - | 890 | 18.8 | 75.8 | [112] |
| DGEBA/EHEP 10 wt.%/DDM | 31.0 | V-0 | 339 (−61.9%) | 11.4 (−11.7%) | 35.7 (−52.9%) | |
| E-51 (200 g/equiv.)/D230 | 21.0 | - | 1271 | 40.5 | 97.4 | [115] |
| EHEP/D230 | 31.0 | V-0 | 426 (−66%) | 8.9 (−78%) | 34.4 (−65%) |
| Epoxy Resin | Hardener | LOI, % | PHRR, kW/m2 | THR, MJ/m2 | TSP, m2 |
|---|---|---|---|---|---|
| E-51 | Diethylene triamine | 21.4 | 798 | 127 | 24 |
| HCCP-SA (20 wt.%) + diethylene triamine | 27.1 | 537 (−32.7%) | 77 (−39.4%) | 12 (−50%) |
| Flame Retardant | Reagents | Stages | Advantages | Disadvantages | Cost of Reagents |
|---|---|---|---|---|---|
| BOPOA | DOPO, diallylamine, absolute ethanol | -preparation of raw materials and equipment; -dissolution of DOPO in ethanol; -loading diallylamine; -synthesis of BOPOA; -distillation; -drying | One-stage synthesis, does not require filtration and washing stages, only ethanol rectification, ease of technological design. | Long synthesis time (9–15 h). Diallylamine is toxic on contact with skin, causes burns, is highly flammable. | DOPO 80 USD/100 g, diallylamine 35 USD/100 mL, ethanol 28 USD/100 mL (Sigma Aldrich) Sum: USD 143 |
| DOPO-CC | DOPO, 4,4′-diaminodiphenylmethane, 3-cyclohexene-1-formaldehyde, tetrahydrofuran (THF) | -preparation of raw materials and equipment; -dissolution of DOPO and 4,4′-diaminodiphenylmethane in THF; -loading 3-cyclohexene-1-formaldehyde; -synthesis of DOPO-CC; -distillation; -drying | One-stage synthesis, does not require filtration and washing stages, only THF rectification, ease of technological design, low synthesis time (6 h). | Tetrahydrofuran is highly flammable | DOPO 80 USD/100 g, 4,4′-diaminodiphenylmethane 60 USD/100 g, 3-cyclohexene-1-formaldehyde 57 USD/100 g, tetrahydrofuran 10 USD/100 g. Sum: USD 207 |
| DCM | 2,4,6-tris(dimethylaminomethyl)phenol, diphenylphosphinic chloride, tetrahydrofuran, triethylamine | -preparation of raw materials and equipment; -dissolution of 2,4,6-tris(dimethylaminomethyl)phenol in THF; -dissolution of diphenylphosphinic chloride in THF; -mixing; -synthesis of DCM; -filtration by Nutsche filter; -distillation; -drying | One-stage synthesis, low synthesis time (5 h), high yield 93% | Tetrahydrofuran is highly flammable, requires filtration stage. | 2,4,6-tris(dimethylaminomethyl)phenol 120 USD/100 g, diphenylphosphinic chloride 800 USD/100 mL, tetrahydrofuran 10 USD/100 mL, triethylamine 29 USD/100 mL. Sum: USD959 |
| HCCP-SA | Hexachlorocyclotriphosphazene, tetrahydrofuran, salicylamide, triethylamine | -preparation of raw materials and equipment; -dissolution of hexachlorocyclotriphosphazene in THF; -addition salicylamide and thriethylamine; -synthesis of HCCP-SA; -distillation; -washing with n-heptane and deionized water 3 times; -drying | One-stage synthesis | Tetrahydrofuran is highly flammable, requires washing stage. | Hexachlorocyclotriphosphazene 190 USD/100 g, tetrahydrofuran 10 USD/100 mL, salicylamide 30 USD/100 g, triethylamine 29 USD/100 mL Sum: USD 255 |
| 4-(β-carboxyethenyl)phenoxy-phenoxycyclotriphosphazene from [130] | Hexachlorocyclotriphosphazene, phenol, tetrahydrofuran, potassium carbonate, 4-hydroxybenzaldehyde, chloroform, potassium hydroxide, water, malonic acid, pyridine, piperidine, hydrochloric acid | -preparation of raw materials and equipment; -dissolution of hexachlorocyclotriphosphazene and phenol in THF; -synthesis of chlorophenoxycyclotruphosphazenes, not isolating; -adding of 4-hydroxybenzaldehyde and potassium carbonate; -synthesis of 4-formylphenoxy-phenoxycyclotriphosphazene; -filtration, precipitation with water; -wasing by aqueous solution of potassium hydroxide and water; -distillation; -drying; Second stage: -preparation of raw materials and equipment; -loading 4-formylphenoxy-phenoxycyclotriphosphazene, malonic acid, pyridine and piperidine; -synthesis; -precipitation with 1 M hydrochloric acid; -filtartion; -washing with distilled water; -drying | High yield | Two-stage synthesis, requires washing stages. | Hexachlorocyclotriphosphazene 190 USD/100 g, phenol 43 USD/100 g, tetrahydrofuran 10 USD/100 mL, potassium carbonate 31 USD/100 g, 4-hydroxybenzaldehyde 21 USD/100 g, potassium hydroxide 7 USD/100 g, malonic acid 67 USD/100 g, pyridine 83 USD/100 mL, piperidine 30 USD/100 mL Sum: USD 482 |
Disclaimer/Publisher’s Note: The statements, opinions and data contained in all publications are solely those of the individual author(s) and contributor(s) and not of MDPI and/or the editor(s). MDPI and/or the editor(s) disclaim responsibility for any injury to people or property resulting from any ideas, methods, instructions or products referred to in the content. |
© 2025 by the authors. Licensee MDPI, Basel, Switzerland. This article is an open access article distributed under the terms and conditions of the Creative Commons Attribution (CC BY) license (https://creativecommons.org/licenses/by/4.0/).
Share and Cite
Yudaev, P.; Tamboura, B.; Konstantinova, A.; Babu, H.V.; Muralidharan, K. Epoxy Resins and Their Hardeners Based on Phosphorus–Nitrogen Compounds. J. Compos. Sci. 2025, 9, 277. https://doi.org/10.3390/jcs9060277
Yudaev P, Tamboura B, Konstantinova A, Babu HV, Muralidharan K. Epoxy Resins and Their Hardeners Based on Phosphorus–Nitrogen Compounds. Journal of Composites Science. 2025; 9(6):277. https://doi.org/10.3390/jcs9060277
Chicago/Turabian StyleYudaev, Pavel, Bakary Tamboura, Anastasia Konstantinova, Heeralal Vignesh Babu, and Krishnamurthi Muralidharan. 2025. "Epoxy Resins and Their Hardeners Based on Phosphorus–Nitrogen Compounds" Journal of Composites Science 9, no. 6: 277. https://doi.org/10.3390/jcs9060277
APA StyleYudaev, P., Tamboura, B., Konstantinova, A., Babu, H. V., & Muralidharan, K. (2025). Epoxy Resins and Their Hardeners Based on Phosphorus–Nitrogen Compounds. Journal of Composites Science, 9(6), 277. https://doi.org/10.3390/jcs9060277
















